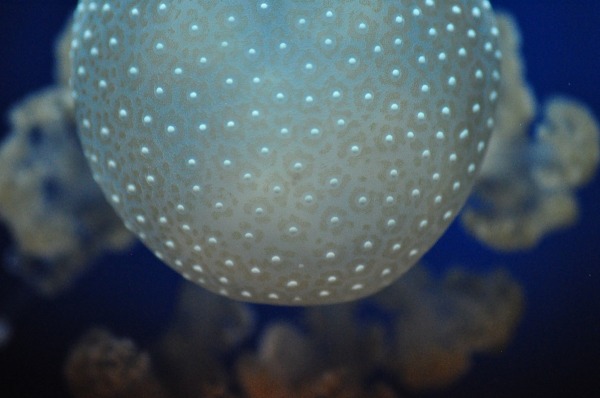
Foto

| Accetta Cookie | Personalizza | Rifiuta Cookie |
|
| Ordina per data |

JuzaPhoto contiene link affiliati Amazon ed Ebay e riceve una commissione in caso di acquisto attraverso link affiliati.
JuzaPhoto contiene link affiliati Amazon ed Ebay e riceve una commissione in caso di acquisto attraverso link affiliati.Possa la Bellezza Essere Ovunque Attorno a Me